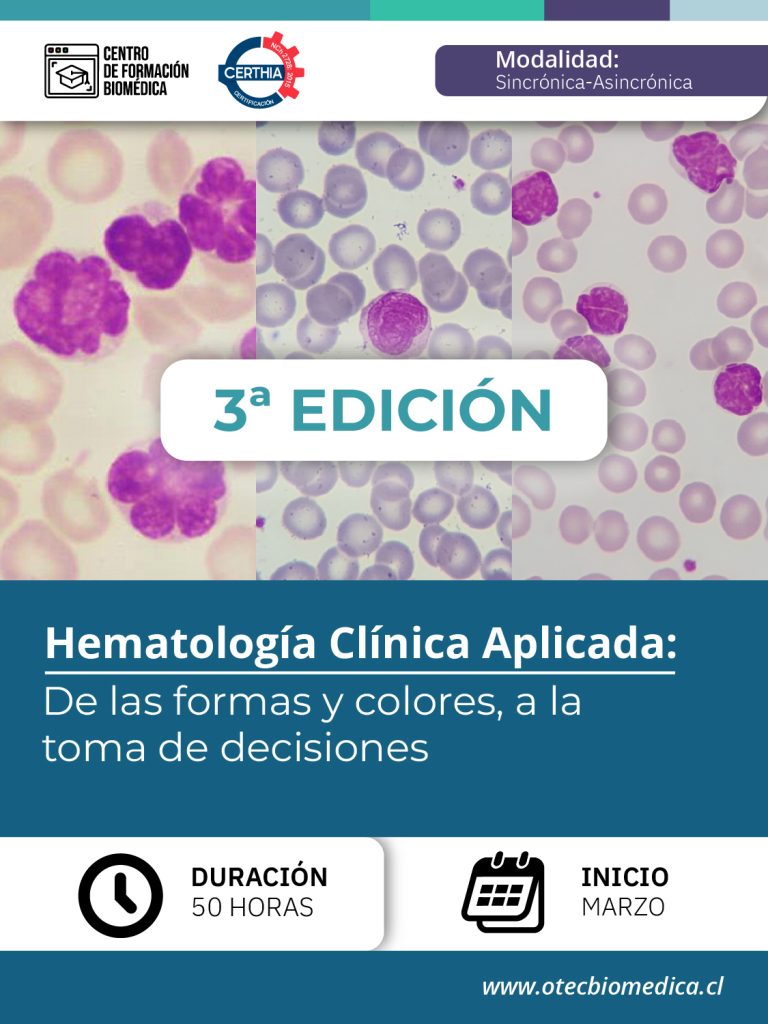

- INFORMACIÓN GENERAL
I. DESCRIPCIÓN DEL CURSO
El curso
«Hematología Clínica Aplicada: De las formas y colores, a la toma de decisiones», en modalidad e-learning, está dirigido a profesionales del área de la salud que buscan perfeccionar sus conocimientos en morfología hematológica, análisis de frotis de sangre periférica e interpretación del hemograma. A través de clases sincrónicas y asincrónicas, talleres prácticos, análisis de casos clínicos y evaluación, los participantes desarrollarán herramientas clínicas y técnicas aplicadas al diagnóstico hematológico. Al finalizar, estarán preparados para abordar y resolver casos con un enfoque reflexivo, integrando calidad analítica y criterio clínico.
II. MODALIDAD
Modalidad 100% online, combinando sesiones sincrónicas y asincrónicas mediante el uso de metodologías activas, análisis de casos, discusión en foros y evaluaciones prácticas. Plataforma e-learning moderna y amigable.
III. OBJETIVOS ESPERADOS
Objetivo General
Fortalecer competencias clínicas y analíticas en hematología, con énfasis en el estudio morfológico y la integración de datos del hemograma para la toma de decisiones diagnósticas en el laboratorio clínico.
Objetivos Específicos
-
Interpretar morfología celular en sangre periférica desde una perspectiva clínica.
-
Aplicar técnicas tintoriales, preanalíticas y de microscopía con estándares de calidad.
-
Identificar alteraciones en las tres series hematológicas: eritrocítica, leucocitaria y plaquetaria.
-
Correlacionar hallazgos microscópicos con resultados de laboratorio y datos clínicos.
-
Analizar casos clínicos simulados o reales mediante pensamiento crítico y trabajo colaborativo.
-
Desarrollar habilidades en redacción técnica, control de calidad e introducción a metodologías Seis Sigma.
IV. A QUIEN VA DIRIGÍDO
Este curso está dirigido a
Tecnólogos Médicos, Médicos y profesionales del área de la salud que se desempeñan o se están formando en contextos clínicos y/o de laboratorio, y que desean actualizar sus conocimientos en hematología morfológica aplicada al diagnóstico.
Si deseas saber más del curso, accede a nuestro BROCHURE aquí:

Información general del curso [BROCHURE]
En caso de consultas, contáctanos a través de nuestra página o a nuestro correo contacto@web.otecbiomedica.cl
El Centro de Formación Biomédica se reserva el derecho de suspender la apertura del programa si no cuenta con el mínimo de estudiantes requeridos.